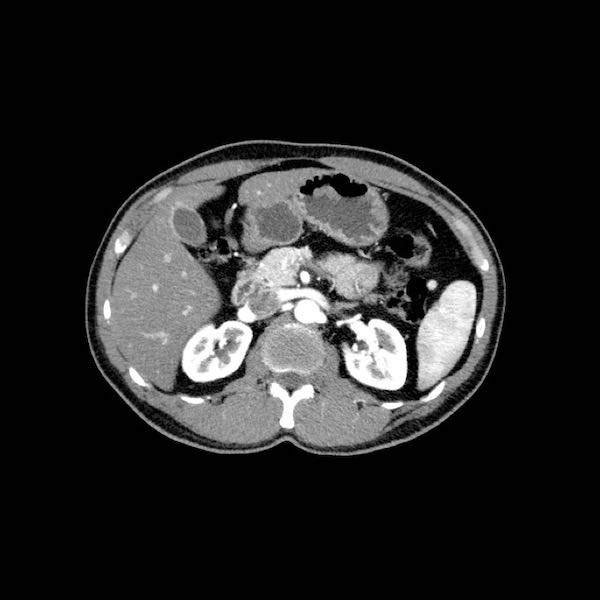
Slider image 20
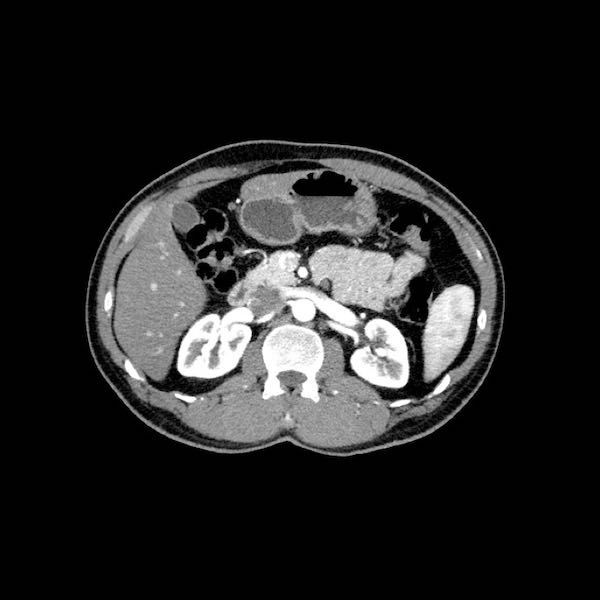
Slider image 24

Ung thư tụy – Phân giai đoạn CT 2.0
Ngày xuất bản
Đây là phiên bản thứ hai về vai trò của CT trong phân giai đoạn ung thư tụy.
Ung thư tụy là nguyên nhân gây tử vong do ung thư đứng hàng thứ tư tại Hoa Kỳ và châu Âu, với hơn 100.000 ca tử vong mỗi năm chỉ riêng tại châu Âu.
Tỷ lệ sống sót toàn bộ sau 5 năm dao động từ 2–7% và hầu như không cải thiện trong hai thập kỷ qua.
Khoảng 15% tổng số bệnh nhân được đánh giá là có khả năng cắt bỏ được tại thời điểm chẩn đoán, và trong số đó, chỉ một phân nhóm nhỏ thực sự có khối u có thể cắt bỏ được khi thám sát phẫu thuật.
Trong bài viết này, chúng tôi sẽ tập trung vào các tiêu chí xác định khả năng cắt bỏ và không thể cắt bỏ, đồng thời cung cấp một bảng kiểm giúp bạn lập báo cáo có cấu trúc cho việc phân giai đoạn ung thư tụy và xác định khả năng phẫu thuật cắt bỏ.
Ở cuối bài viết sẽ có các video của Frank Wessels hướng dẫn cách phân giai đoạn ung thư tụy.
Giới thiệu
Phẫu thuật cắt bỏ hoàn toàn khối u là phương pháp điều trị triệt căn duy nhất, tuy nhiên ung thư tụy hiếm khi được phát hiện ở giai đoạn sớm, do 40% bệnh nhân đã có di căn xa và 40% biểu hiện với ung thư tụy tiến triển tại chỗ (LAPC – Locally Advanced Pancreatic Cancer), vốn không thể cắt bỏ được.
- Kích thước khối u
- Mức độ xâm lấn các cấu trúc mạch máu quan trọng theo tiêu chí NCCN hoặc DPCG
- Xâm lấn các cấu trúc lân cận như mạc treo đại tràng ngang, gốc mạc treo ruột và xâm lấn quanh thần kinh
- Tình trạng hạch bạch huyết vùng hoặc ngoài vùng
Các vấn đề này sẽ được thảo luận chi tiết hơn trong chương tiếp theo về phân giai đoạn.
Dựa trên các kết quả hình ảnh, khối u có thể được phân loại là: có thể cắt bỏ, có thể cắt bỏ ở ranh giới, hoặc không thể cắt bỏ.
Phân giai đoạn
Đánh giá mức độ xâm lấn mạch máu
Sự xâm lấn các cấu trúc mạch máu quan trọng là yếu tố quyết định nhất đến khả năng cắt bỏ của ung thư biểu mô tuyến tụy (hình).
Đồng thời, đây cũng là yếu tố tiên lượng quan trọng về thời gian sống còn.
Tiêu chí đánh giá khả năng cắt bỏ dựa trên mức độ xâm lấn mạch máu được sử dụng phổ biến nhất là tiêu chí của Mạng lưới Ung thư Toàn diện Quốc gia (NCCN).
Tuy nhiên, các tiêu chí này khá phức tạp, do đó nhiều tiêu chí khác cũng đã được đề xuất.
Chẳng hạn, tại Hà Lan, chúng tôi áp dụng tiêu chí của Nhóm Ung thư Tụy Hà Lan (DPCG).
Chúng tôi sẽ trình bày tiêu chí DPCG trước, sau đó đến tiêu chí NCCN.
Dù áp dụng tiêu chí nào, cần nhận thức rằng việc đánh giá khả năng cắt bỏ mang tính chủ quan và có sự khác biệt giữa các cơ sở y tế, đặc biệt trong trường hợp tái tạo hệ tĩnh mạch cửa.
Tiêu chí đánh giá khả năng cắt bỏ của DPCG
Tiêu chí của Nhóm Ung thư Tụy Hà Lan về mức độ xâm lấn mạch máu tương đối đơn giản hơn so với tiêu chí NCCN, đó là lý do chúng tôi trình bày tiêu chí này trước (bảng).
Khả năng cắt bỏ còn được xác định dựa trên sự hiện diện của di căn xa và tình trạng hạch bạch huyết, trong đó các hạch ngoài vùng được xem là di căn xa.
Các phát hiện bổ sung quan trọng mà phẫu thuật viên cần lưu ý, dễ bị bỏ sót, bao gồm:
- Xâm lấn quanh thần kinh
- Xâm lấn gốc mạc treo ruột
- Xâm lấn mạc treo kết tràng
Các phát hiện này sẽ được thảo luận trong chương tiếp theo.
Tiêu chí đánh giá khả năng cắt bỏ của NCCN
Không thể cắt bỏ tại chỗ đồng nghĩa với ung thư tụy tiến triển tại chỗ (LAPC).
Đánh giá mức độ xâm lấn mạch máu theo chu vi được thực hiện theo từng bước 90 độ.
Tiếp xúc dưới 180 độ được gọi là áp sát (abutment) và tiếp xúc trên 180 độ được gọi là bao quanh (encasement).
Xác suất xâm lấn mạch máu là 40% đối với áp sát và 80% đối với bao quanh, có thể lên đến 100% khi khối u bao quanh hoàn toàn tĩnh mạch cửa hoặc tĩnh mạch mạc treo tràng trên (SMV).
Trong trường hợp xâm lấn tĩnh mạch, chiều dài đoạn xâm lấn cũng cần được ghi nhận vì điều này có thể giúp phẫu thuật viên đánh giá khả năng tái tạo mạch máu.
Độ đặc hiệu của CT trong phát hiện xâm lấn mạch máu dao động từ 82-100% và độ nhạy từ 70-96%.
Việc sử dụng tái tạo đa mặt phẳng (multiplanar reformation) giúp cải thiện hiệu quả chẩn đoán tổng thể của CT, như được minh họa trong trường hợp này.
Tái tạo mặt phẳng coronal cho thấy một khối u nhỏ ở đầu tụy (đầu mũi tên) gây tắc nghẽn ống mật chủ.
Có vẻ chỉ có tiếp xúc hạn chế với tĩnh mạch cửa (mũi tên).
Tiếp tục xem các hình ảnh tiếp theo.
Tái tạo đa mặt phẳng vuông góc với tĩnh mạch cửa cho thấy mức độ tiếp xúc với tĩnh mạch cửa rộng hơn, từ 90 đến 180 độ (mũi tên).
Khi không có bất thường bờ viền, trường hợp này được phân loại là có thể cắt bỏ giới hạn (borderline resectable) theo tiêu chí DPCG, nhưng có thể cắt bỏ (resectable) theo tiêu chí NCCN.
Phẫu thuật cắt bỏ không kèm tái tạo tĩnh mạch cho kết quả R1, tức là có xâm lấn vi thể của khối u tại diện cắt.

Dấu hiệu giọt nước mắt. Khối u lớn ở thân tụy, tiếp xúc 90 – 180 độ với SMV, đồng thời gây biến dạng SMV thành hình giọt nước mắt, rất nghi ngờ xâm lấn.
Các thay đổi hình thái gợi ý xâm lấn mạch máu
- Dấu hiệu giọt nước mắt (Teardrop sign)
Chỉ sự thay đổi hình dạng của tĩnh mạch cửa (PV) hoặc SMV từ hình bầu dục hoặc tròn sang hình giọt nước mắt. Điều này có thể do khối u bao quanh hoặc do xơ hóa lân cận kéo căng mạch máu. - Bất thường bờ viền mạch máu
Bờ viền không đều của mạch máu gợi ý xâm lấn mạch máu. Dấu hiệu này có giá trị hơn đối với động mạch, do thành động mạch dày hơn thành tĩnh mạch. - Huyết khối
Sự hiện diện của huyết khối trong động mạch gợi ý xâm lấn mạch máu.
Bất thường bờ viền mạch máu
CT axial cho thấy:
- Khối u ở thân tụy (đầu mũi tên trắng).
- Tiếp xúc khu trú < 90º với động mạch mạc treo tràng trên (SMA).
- Tiếp xúc rộng hơn từ 90º – 180º với SMV, SMV bị hẹp nhẹ và biến dạng (mũi tên vàng).
- Giãn ống tụy
Tái tạo mặt phẳng coronal cho thấy:
- Bất thường bờ viền thành SMV được nhận thấy rõ hơn trên tái tạo coronal này (mũi tên).
- Khối u ở thân tụy (đầu mũi tên trắng).
- Huyết khối trong các nhánh bên của SMV (mũi tên xanh nhỏ).
Tái tạo mặt phẳng coronal cho thấy một khối u lớn xuất phát từ cổ tụy với kiểu phát triển xâm lấn (hình A và B).
Có hiện tượng bao quanh động mạch thân tạng 360º (mũi tên trong A).
CT axial MIP tại mức động mạch thân tạng cho thấy hẹp động mạch gan chung bị bao quanh (mũi tên), rất nghi ngờ xâm lấn.
Vị trí
65% ung thư biểu mô tuyến tụy nằm ở đầu tụy, 15% ở thân tụy và 10% ở đuôi tụy. 10% còn lại là đa ổ hoặc lan tỏa (hình).
Khối u ở đầu tụy thường biểu hiện sớm hơn do vàng da tắc mật. Khối u ở thân và đuôi tụy thường biểu hiện muộn và có tiên lượng xấu hơn.
Giai đoạn T
Phân giai đoạn T đã được đơn giản hóa trong tiêu chí TNM-8 của AJCC.
Giai đoạn T không quyết định khả năng cắt bỏ khối u mà chủ yếu mang ý nghĩa tiên lượng.
Các phân loại T2 và T3 hiện nay chỉ dựa trên kích thước và sự xâm lấn ngoài tụy không còn là một phần của định nghĩa.
Lý do là các định nghĩa dựa trên kích thước mang tính khách quan hơn, vì việc xác định xâm lấn ngoài tụy thường khó khăn.
Phân loại T4 hiện nay dựa trên mức độ xâm lấn động mạch.
Khả năng cắt bỏ đã được loại khỏi định nghĩa vì đây là tiêu chí mang tính chủ quan và có sự khác biệt giữa các cơ sở y tế.
Giai đoạn N
Điều quan trọng là phân biệt giữa hạch bạch huyết vùng và hạch bạch huyết ngoài vùng (di căn xa).
Các vị trí ngoài vùng chính là cạnh động mạch chủ và bên trái SMA.
Các hạch nghi ngờ ở những vị trí này cần được ghi nhận và sinh thiết.
Trong hình minh họa này, chúng tôi sử dụng các trạm hạch bạch huyết trong ung thư tụy theo đề xuất của Hội Tụy học Nhật Bản.
Danh sách đầy đủ được cung cấp trong chương về báo cáo. Nhấn vào đây.
Di căn hạch bạch huyết là yếu tố tiên lượng quan trọng và xảy ra ở khoảng hai phần ba bệnh nhân ung thư tụy có khả năng cắt bỏ.
Các biến thể giải phẫu động mạch
Các biến thể giải phẫu
Giải phẫu động mạch gan được coi là bình thường chỉ gặp ở 55% dân số (hình minh họa).
Các biến thể giải phẫu động mạch gan được ghi nhận ở khoảng 40-45% dân số.
Các động mạch bất thường có thể đi qua vùng lân cận đầu tụy, làm tăng nguy cơ xâm lấn của khối u hoặc tổn thương do phẫu thuật.
Các động mạch gan có nguyên ủy bất thường có thể là dạng phụ thêm (accessory) hoặc dạng thay thế (replaced).
Động mạch gan phải phụ thêm là một động mạch gan phải bổ sung, trong khi động mạch gan phải thay thế có nguyên ủy bất thường và thay thế hoàn toàn cho động mạch gan phải chính thức (hình minh họa).
Các biến thể phổ biến nhất được trình bày trong hình vẽ minh họa.
Ở những bệnh nhân dự kiến phẫu thuật tụy, điều quan trọng là cần đặc biệt chú ý tìm kiếm nguyên ủy bất thường của động mạch gan phải hoặc động mạch gan chung.
Các động mạch này xuất phát từ phía phải của động mạch mạc treo tràng trên (SMA) và đi qua vùng lân cận đầu tụy, làm tăng nguy cơ xâm lấn của khối u hoặc tổn thương do phẫu thuật.
Tần suất được ghi nhận của các bất thường đặc hiệu này lần lượt là 11-21% và 0,5-5%.
Hình CT axial cho thấy một động mạch gan phải phụ thêm (mũi tên vàng) đi qua vùng lân cận một khối giảm tỷ trọng ở đầu tụy (đầu mũi tên).
Sự liên quan mạch máu được đánh giá rõ hơn trên ảnh tái tạo mặt phẳng đứng dọc. Có sự áp sát 90 – 180° của động mạch gan phải thay thế (mũi tên trắng) bởi ung thư biểu mô tuyến đầu tụy (đầu mũi tên trắng).
Động mạch gan trái nguyên bản đi theo hướng ra trước hơn, tĩnh mạch cửa nằm ở giữa.
Cuộc phẫu thuật là cắt bỏ diện R1.
Các hình ảnh axial của cùng bệnh nhân có chú thích.
Hình MIP mặt phẳng đứng ngang này cho thấy một động mạch gan phải thay thế xuất phát từ phía phải của SMA (mũi tên vàng trong A).
Động mạch này đi qua vùng lân cận đầu tụy.
Hình CT axial cho thấy đường đi của động mạch gan phải thay thế phía sau tĩnh mạch cửa (đầu mũi tên vàng) và động mạch gan trái nguyên bản đi phía trước tĩnh mạch cửa (đầu mũi tên xanh lá).
Đây là phát hiện tình cờ ở một bệnh nhân không có bệnh lý tụy.
Các hình ảnh mặt phẳng đứng ngang của một bệnh nhân có khối u ở đầu tụy và động mạch gan phải phụ thêm.
Lưu ý sự áp sát của động mạch phụ thêm bởi khối u.
Các hình ảnh cho thấy một biến thể giải phẫu trong đó động mạch gan chung xuất phát hoàn toàn từ SMA.
Động mạch gan được thấy đi trong nhu mô đầu tụy (mũi tên vàng và xanh lá trong B).
Hẹp động mạch
Bước tiếp theo trong đánh giá tiền phẫu là tìm kiếm hẹp động mạch thân tạng, được ghi nhận ở 2-8% bệnh nhân trải qua phẫu thuật cắt tụy-tá tràng.
Hẹp động mạch thân tạng có thể do chèn ép bởi dây chằng cung giữa hoặc do bệnh lý xơ vữa động mạch.
Hẹp đáng kể động mạch thân tạng thường được bù trừ bởi dòng máu bàng hệ từ SMA, qua cung động mạch quanh tụy (của Buhler) và dòng chảy ngược trong động mạch vị-tá tràng. Do động mạch vị-tá tràng bị cắt bỏ trong quá trình phẫu thuật cắt tụy-tá tràng, nguồn cung cấp máu động mạch cho gan sẽ bị đe dọa nếu hẹp động mạch thân tạng không được phát hiện trước phẫu thuật.
Hình ảnh
Hình tái tạo mặt phẳng đứng ngang (a) cho thấy một khối u nhỏ ở vùng bóng Vater (đầu mũi tên), gây tắc nghẽn cả ống mật chủ (CBD) và ống tụy (PD). Khi không có xâm lấn tại chỗ, tổn thương này được xem là có thể cắt bỏ được.
Tuy nhiên, hình CT axial (b) cho thấy phì đại của cung động mạch quanh tụy (các mũi tên), gợi ý mạnh hẹp đáng kể thân tạng.
Hẹp thân tạng được thể hiện trên hình MIP mặt phẳng đứng dọc (mũi tên trong c).
Dòng máu bàng hệ đến động mạch gan qua cung động mạch tụy-tá tràng (mũi tên nét đứt) được quan sát rõ trên hình MIP mặt phẳng đứng ngang (d).
Tái phân giai đoạn sau điều trị tân bổ trợ

CT theo dõi sau điều trị tân bổ trợ không ghi nhận tiến triển bệnh và đã tiến hành phẫu thuật thăm dò.
Trong thời đại điều trị tân bổ trợ, việc tái phân giai đoạn đã trở thành một chủ đề được quan tâm sâu sắc và bộc lộ một số hạn chế quan trọng, chủ yếu trong việc phân biệt xơ hóa còn lại với khối u còn hoạt tính.
Tái phân giai đoạn trên CT thường đánh giá quá mức kích thước khối u và do đó đánh giá thấp mức độ đáp ứng điều trị; vì vậy các phép đo theo tiêu chí RECIST có rất ít hoặc không có giá trị trong trường hợp không có tiến triển bệnh. Hơn nữa, mức độ xâm lấn mạch máu cũng thường bị đánh giá quá mức, tồn tại dai dẳng ở 80% bệnh nhân, nhưng có thể là xơ hóa thay vì khối u còn hoạt tính.
Bất kỳ sự giảm thiểu nào trong diện tiếp xúc giữa mạch máu và khối u đều được chứng minh có liên quan có ý nghĩa thống kê với khả năng cắt bỏ đạt diện cắt R0, gợi ý rằng dấu hiệu này có thể được xem là chỉ định phẫu thuật cắt bỏ ở những bệnh nhân phù hợp.
Vai trò của CT tái phân giai đoạn tại thời điểm này là nhằm loại trừ tiến triển bệnh; nếu không có tiến triển, cần cân nhắc phẫu thuật thăm dò. Dữ liệu về giá trị bổ sung của chuỗi xung khuếch tán (DWI) hoặc PET-CT vẫn còn hạn chế.
Hình ảnh
CT axial (a) trước điều trị tân bổ trợ cho thấy khối u ở mặt trong đầu tụy (đầu mũi tên), không thể cắt bỏ do xâm lấn thần kinh lan rộng với mức độ bao quanh 360 độ động mạch mạc treo tràng trên (SMA) (mũi tên trong b, tái tạo mặt phẳng coronal).
CT theo dõi sau 8 chu kỳ FOLFIRINOX (c,d) cho thấy bệnh ổn định với tình trạng bao quanh SMA vẫn còn tồn tại. Khối u được đánh giá có thể cắt bỏ trong quá trình phẫu thuật nội soi thăm dò. Kết quả giải phẫu bệnh: T3bN2R0.
Chẩn đoán hình ảnh
Quy trình chụp CT
Đánh giá giai đoạn tại chỗ cần được thực hiện bằng CT tụy chất lượng cao, bao gồm thì động mạch muộn và thì tĩnh mạch cửa.
Ung thư biểu mô tuyến tụy thường biểu hiện là một khối giảm tỷ trọng, kém mạch máu, được nhận thấy rõ nhất ở thì động mạch muộn. Đây cũng là thì tốt nhất để đánh giá giải phẫu động mạch nhằm phát hiện các biến thể và hẹp mạch.
Thì tĩnh mạch cửa là tốt nhất để phát hiện di căn gan cũng như phát hiện hẹp và xâm lấn tĩnh mạch.
Để xem khuyến nghị về quy trình chụp, nhấp vào đây
CT là phương tiện chủ lực trong phân giai đoạn ung thư biểu mô tuyến tụy.
Đây là phương pháp được sử dụng rộng rãi nhất và được kiểm chứng tốt nhất.
CT có thể đánh giá mức độ xâm lấn tại chỗ và di căn xa, với độ chính xác lên đến 77% trong dự đoán khả năng cắt bỏ được và 93% trong dự đoán khả năng không cắt bỏ được.
Vai trò của MRI
MRI được sử dụng để đặc trưng hóa các tổn thương gan chưa xác định rõ bản chất trên CT; hiện tại chưa có bằng chứng ủng hộ việc áp dụng MRI để đánh giá giai đoạn gan thường quy cho tất cả bệnh nhân.
Ngoài ra, MRI có thể được sử dụng để đặc trưng hóa các tổn thương tụy chủ yếu dạng nang, một chủ đề nằm ngoài phạm vi của bài viết này.
MRI cho phép phát hiện di căn gan tốt hơn, với độ nhạy được báo cáo từ 85-100%. Trong đó, 10-25% các trường hợp MRI phát hiện di căn gan sau khi CT ban đầu âm tính. Tuy nhiên, các dữ liệu này dựa trên các nghiên cứu hồi cứu quy mô nhỏ.
Trong kỷ nguyên điều trị tân bổ trợ, vai trò của MRI vẫn còn đang được tranh luận, do thực tế là hơn 40% các tổn thương gan nhỏ không thể lấy được bằng chứng mô học qua sinh thiết xuyên da.
Điều trị phẫu thuật
Phẫu thuật Whipple
Phẫu thuật Whipple là một phẫu thuật trong đó đầu tụy cùng với khối ung thư và đoạn xa của ống mật chủ được cắt bỏ, kết hợp với một phần nhỏ đoạn xa dạ dày, toàn bộ tá tràng và một phần nhỏ đoạn đầu hỗng tràng.
Dạ dày, đoạn gần ống mật chủ và thân tụy được nối với hỗng tràng.
Cắt tụy-tá tràng bảo tồn môn vị
Cắt tụy-tá tràng bảo tồn môn vị (PPPD) về cơ bản là phẫu thuật tương tự nhưng có bảo tồn môn vị.
Cắt tụy đoạn xa hoặc cắt tụy trái
Phẫu thuật áp dụng cho khối u ở thân hoặc đuôi tụy. Phẫu thuật có thể thực hiện kèm hoặc không kèm cắt lách.
Cắt tụy toàn bộ
Kết hợp giữa phẫu thuật Whipple và cắt tụy đoạn xa.
Báo cáo kết quả
Danh mục kiểm tra
Danh sách này bao gồm tất cả các mục cần được đánh giá.
Trong phần kết luận của báo cáo chẩn đoán hình ảnh, cần đề cập đến các mục quan trọng nhất.
Các chặng hạch bạch huyết trong ung thư tụy
Các chặng hạch bạch huyết trong ung thư tụy theo đề xuất của Hội Tụy học Nhật Bản.
Video trình bày bởi Frank Wessels
Ca 1 – Ung thư có thể phẫu thuật cắt bỏ
Đây là ca lâm sàng số 1 trong chuỗi video minh họa cách phân giai đoạn ung thư tụy.
Các video tiếp theo sẽ sớm được cập nhật.